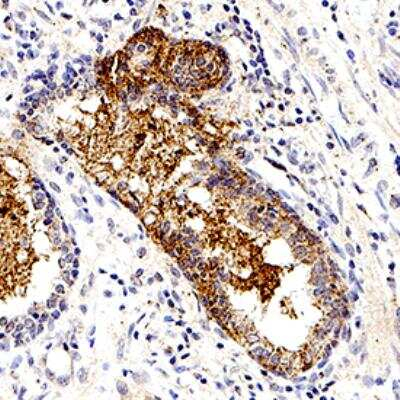
S-arrestin Antibody in Immunohistochemistry (Paraffin) (IHC (P))

Search
Invitrogen
S-arrestin Monoclonal Antibody (PDS-1)
{{$productOrderCtrl.translations['antibody.pdp.commerceCard.promotion.promotions']}}
{{$productOrderCtrl.translations['antibody.pdp.commerceCard.promotion.viewpromo']}}
{{$productOrderCtrl.translations['antibody.pdp.commerceCard.promotion.promocode']}}: {{promo.promoCode}} {{promo.promoTitle}} {{promo.promoDescription}}. {{$productOrderCtrl.translations['antibody.pdp.commerceCard.promotion.learnmore']}}
图: 1 / 2
S-arrestin Antibody (MA1-16962) in IHC (P)


Please note: We are reviewing Western blot images included in the antibody testing data in our catalog, including those provided by third parties. Unless expressly labeled or annotated as “raw-unedited”, Western blot images included in the antibody testing data in our catalog may have been edited, optimized or otherwise adjusted for presentation.
产品信息
MA1-16962
种属反应
宿主/亚型
分类
类型
克隆号
抗原
偶联物
形式
浓度
规格
纯化类型
保存液
内含物
保存条件
运输条件
RRID
产品详细信息
Suggested positive control: retina lysate.
靶标信息
S-arrestin, also known as retinal arrestin or visual arrestin, is part of a small gene family that includes four members. It primarily functions in the retina, specifically within rod and cone photoreceptors. S-arrestin plays a crucial role in phototransduction by participating in the inactivation of opsin, which is a key component in the visual signaling pathway. Upon light stimulation, activated opsin interacts with a G-protein-coupled receptor kinase (GRK), leading to its phosphorylation. S-arrestin then binds to phosphorylated opsin to terminate the G-protein signaling, hence contributing to the process of vision adaptation and regulation of neurotransmitter release at the photoreceptor-bipolar cell synapse. This interaction is vital for the proper functioning of the visual cycle, ensuring that 11-cis-retinal is regenerated through the retinoid cycle. Mutations in the S-arrestin gene, like other rhodopsin alleles, are linked to various retinal disorders. The gene's expression pattern is specific to the retina, underscoring its role in vision, and it is distinct from other members of the arrestin family like beta-arrestins which regulate G-protein-coupled receptors (GPCRs) outside of the retina.
仅用于科研。不用于诊断过程。未经明确授权不得转售。
生物信息学
蛋白别名: 48 kDa protein; arrestin-1; arrestin1; DKFZp686D1084; DKFZp686I1383; photoreceptor protein/alleged cGMP phosphodiesterase activation modulator; retinal S antigen; Retinal S-antigen; Rod photoreceptor arrestin; S-AG; S-antigen; S-antigen; retina and pineal gland (arrestin); S-arrestin
基因别名: S-AG; SAG
UniProt ID: (Pig) P79260, (Bovine) P08168
Entrez Gene ID: (Pig) 397151, (Bovine) 280922